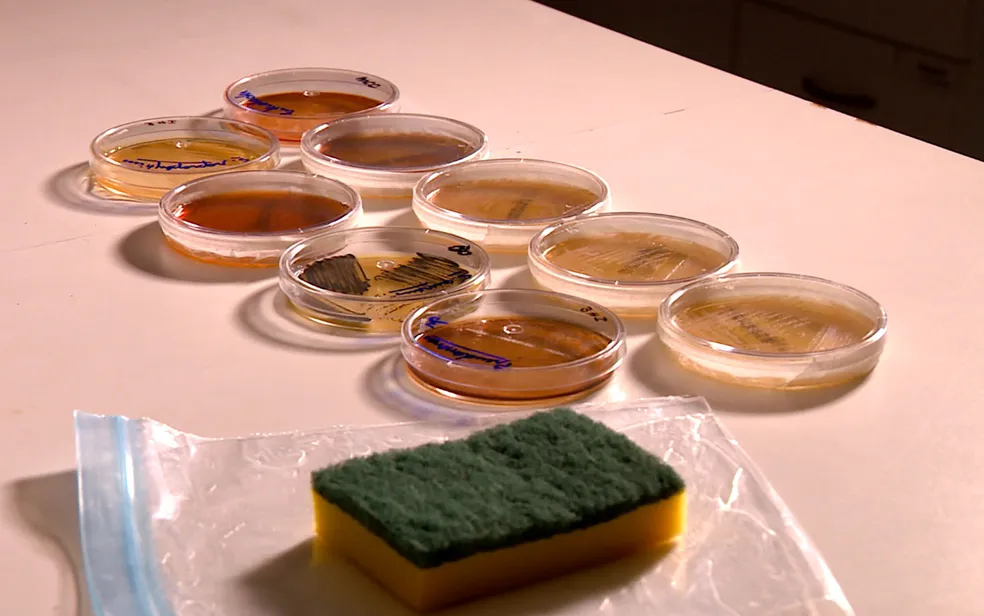

Ei, você! Aquela sua esponja de cozinha, que parece tão inofensiva e ajuda a deixar tudo limpo, pode ser o item mais sujo da sua casa. Sim, a verdade sobre sua esponja é chocante: ela pode abrigar milhões de bactérias, até mais do que o seu vaso sanitário. Mas calma, não entre em pânico! Estamos aqui para descomplicar esse problema e te dar soluções simples.
- Você vai entender por que sua esponja vira um paraíso para bactérias.
- Vai aprender métodos eficazes para desinfetá-la corretamente.
- E saberá a hora certa de dizer adeus a ela para manter sua cozinha segura.
Preparado para desvendar esse mistério e revolucionar a higiene da sua cozinha? Então, continue lendo!
Qual é a Verdade sobre sua Esponja de Cozinha e Por Que Ela é Tão Perigosa?

A primeira coisa que você precisa saber é: sua esponja é uma armadilha perfeita para micro-organismos. Ela é úmida, tem uma estrutura porosa cheia de esconderijos e está em contato constante com restos de comida, o alimento preferido das bactérias.
É um ciclo vicioso: você usa para limpar, ela absorve sujeira e umidade, e o calor do ambiente da cozinha cria um cenário ideal para a proliferação. Bactérias como Salmonella e E. coli, que causam intoxicações alimentares, encontram ali seu lar perfeito.
Estudos, como um realizado em 2017 pela Universidade de Furtwangen, na Alemanha, comprovaram que as esponjas de cozinha podem conter uma densidade altíssima de bactérias – mais de 5 x 1010 células por centímetro cúbico! Isso é um número assustador, e a verdade sobre sua esponja é que ela pode estar espalhando mais sujeira do que limpando.
Como Desinfetar sua Esponja e Eliminar os Invasores Silenciosos?
Agora que você sabe o problema, vamos para a solução! Existem maneiras eficazes de desinfetar sua esponja, e o ideal é fazer isso diariamente ou a cada dois dias. Não subestime o poder de uma boa higienização para garantir a higiene cozinha.
Aqui estão os métodos mais práticos e comprovados:
- Micro-ondas: Umedeça bem a esponja (nunca seca!) e leve ao micro-ondas por 1 a 2 minutos em potência alta. O vapor e o calor matam a maioria das bactérias.
- Fervura: Mergulhe a esponja em água fervente por 5 minutos. É simples e muito eficaz.
- Lava-louças: Se você tem uma máquina, coloque a esponja junto com a louça no ciclo de lavagem mais quente e com secagem.
- Solução de água sanitária: Deixe a esponja de molho em uma solução de 1 parte de água sanitária para 9 partes de água por 5 minutos. Depois, enxágue muito bem.
Com Que Frequência Devo Trocar a Minha Esponja de Cozinha?
Mesmo desinfetando, a esponja não dura para sempre. Ela se desgasta, e com o tempo, sua estrutura se torna ainda mais propícia para abrigar bactérias, mesmo após a limpeza. A regra de ouro é: se ela está rasgada, cheirando mal ou visivelmente suja, jogue fora imediatamente.
Para uma saúde alimentar segura e uma limpeza doméstica eficaz, a recomendação é trocar a esponja semanalmente. Em casos de uso intenso, pode ser até mais cedo. Pense nisso como um investimento na saúde da sua família.
Esponja e Pano de Prato: Separar para Multiplicar a Higiene?
Sim, essa é uma ótima estratégia! Usar a mesma esponja ou pano para tudo na cozinha pode espalhar contaminação. Tenha esponjas e panos diferentes para diferentes tarefas.
Por exemplo, uma esponja para lavar a louça, outra para limpar a pia e bancadas e um pano exclusivo para secar. Essa simples organização eleva o nível da sua higiene cozinha e reduz drasticamente o risco de contaminação cruzada.
A adoção de boas dicas limpeza faz toda a diferença. Lembre-se que cada ferramenta tem seu propósito e tempo de vida útil.
| Método de Desinfecção | Prós | Contras | Frequência Sugerida |
|---|---|---|---|
| Micro-ondas | Rápido, eficaz, fácil | Risco de incêndio se seca, não mata esporos | Diariamente |
| Fervura | Muito eficaz, acessível | Leva mais tempo, consome energia | Diariamente |
| Lava-louças | Prático (se já usar), alta temperatura | Não mata todas as bactérias, consome água/energia | A cada 2-3 dias |
| Água Sanitária | Eficaz, desinfeta bem | Cheiro forte, pode desgastar a esponja | A cada 2-3 dias |
Mantenha a Verdade sobre sua Esponja sob Controle: Seu Guia Prático para uma Cozinha Segura

Chegamos ao final da nossa conversa, e a verdade sobre sua esponja não precisa ser um pesadelo. Pequenas mudanças nos seus hábitos de limpeza podem fazer uma enorme diferença na segurança da sua cozinha e na saúde de todos.
O segredo está na consistência e na atenção aos detalhes. Não ignore os sinais de uma esponja que precisa ser substituída ou desinfetada. Sua cozinha agradecerá, e sua família estará muito mais protegida.
- Desinfete sua esponja diariamente usando um dos métodos que ensinamos.
- Troque a esponja semanalmente ou assim que ela apresentar sinais de desgaste.
- Considere ter esponjas e panos diferentes para usos específicos na cozinha.
Gostou de desvendar mais um mistério do cotidiano conosco? O Adoos.com.br é seu guia prático para descomplicar o mundo e te trazer soluções de bolso.
Continue nos acompanhando para mais dicas, guias e explicações fascinantes que resolvem problemas reais e alimentam sua curiosidade!